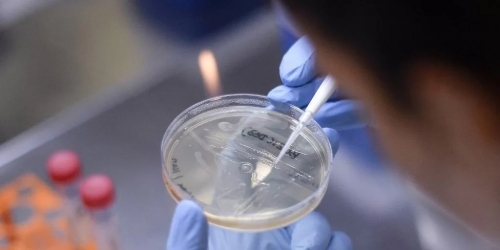

Confira a programação

Estado terá manhã fria e tarde quente

Estimativa está no último Informativo Conjuntural da Emater-Ascar

Acidente ocorreu na manhã deste domingo

Fato ocorreu em Lajeado Boi

Não há informações sobre o tamanho da aglomeração de insetos

Fato ocorreu na tarde deste sábado
Previsão é de 30 milhões de doses entre dezembro e janeiro

Prêmio estava acumulado em R$ 22, 6 milhões